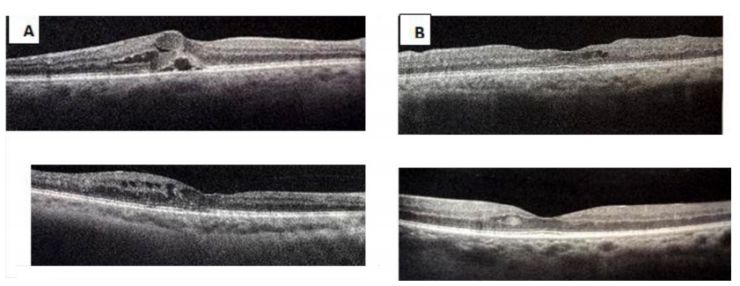
治疗糖尿病眼病吃什么药,高压氧对糖尿病有好处吗

医脉通编译整理,未经授权请勿禁止媒体转载,欢迎个人转发至朋友圈。
导读:近期发表的一项前瞻性研究表明,高压氧治疗(HBOT)可显著改善糖尿病视网膜病变和黄斑水肿。
糖尿病视网膜病变和黄斑水肿是常见的糖尿病微血管并发症,严重可致盲,因此对于此类并发症的预防和早期治疗具有重要意义。近期,有研究人员探究了HBOT疗法对于上述并发症的治疗效果。
本项研究为前瞻性研究,旨在评估HBOT对于伴有糖尿病足溃疡患者的视网膜病变和黄斑水肿的影响。HBOT治疗组共纳入了25名伴有糖尿病足溃疡以及非增生性糖尿病视网膜病变患者(参照ETDRS分级系统);对照组纳入了25名未接受过HBOT治疗的非增生性糖尿病视网膜病变患者(这些参与者未伴有足部溃疡,也未伴有需要接受HBOT治疗的任何指征)。增殖性糖尿病视网膜病变患者以及存在HBOT禁忌的参与者被排除在外。
HBOT治疗方案:每次进行90分钟(2.5ATA),平均每周5次(1天最多进行1次),为期6周,共进行30次。
所有患者在基线时均接受了全面的眼科检查,如最佳矫正视力(BCVA)、眼内压(IOP)、眼底检查、眼底摄影和黄斑部SD-OCT检查。6周后接受第二次检查,研究人员将试验数据进行了分析。
HBOT治疗组最佳矫正视力改善明显
基线时,两组参与者在平均年龄、性别差异、糖尿病控制程度、DR程度方面均无明显差异。
基线时,两组BCVA无统计学差异(P=0.473),但经过6周干预后,HBOT组参与者BCVA有了明显改善(P=0.009,表1),反观对照组出现了一定程度的恶化。
表1 BVCA结果

HBOT治疗组眼内压改善明显
基线时两组眼内压水平无显著差异,经过6周的干预后,HBOT治疗组平均IOP出现显著降低(P<0.001),反观对照组,平均IOP出现了显著升高(P=0.005)。
表2 HBOT治疗前后的眼内压变化

糖尿病视网膜病变改善明显
研究人员比较了第一次和最后一次检查时,参与者DR分期的分布。在HBOT治疗组中,研究人员观察到DR的总体分布趋向于减轻(P<0.001)。然而,在对照组中,严重DR参与者人数由2名增加至4名(P<0.001),这两名参与者为血糖控制不佳的年轻1型糖尿病患者。
表3 HBOT治疗前后DR分期的变化

中央黄斑体厚度改善明显
研究结果表明,HBOT治疗组,中央黄斑体厚度(CMT)相对基线出现了显著降低(P=0.006)。而对照组相比于基线,CMT出现显著升高(P=0.008)。
注:A HBOT治疗前;B HBOT治疗后
图1 经HBOT治疗,糖尿病黄斑水肿得到明显改善
表4 中央黄斑体厚度的变化

讨论与小结
HBOT可用于糖尿病足溃疡的治疗,并且目前已出台了具体的推荐治疗方案。但其还没有明确被推荐用于眼科疾病的治疗。不过,有学者认为糖尿病视网膜病变和黄斑水肿是HBOT疗法的潜在适应证。
是否获得充足的氧是视网膜健康状况的决定因素,试验数据表明,氧供应的增加会带来视力的改善。HBOT治疗会使得患者肺氧分压升高,增加血氧含量,使得缺血区血流增加。之前有报道称,HBOT疗法可用于糖尿病视网膜病变的治疗,其有助于血-视网膜屏障破坏的改善。不过总体来说,评价HBOT对DR影响的研究相对较少。
HBOT治疗也可能会导致一些副作用,如气压伤、肺部氧中毒、神经系统氧中毒、白内障、严重可逆性近视(20%)等,因此为了避免上述不良反应的发生,选择此种治疗方案前,务必核实患者是否伴有相关禁忌证。
总之,本项研究表明,HBOT疗法可改善糖尿病视网膜病变和糖尿病黄斑水肿,这种疗法或许可以作为此类疾病的辅助治疗手段,但考虑到样本量较小,未来还需要大型前瞻性研究予以验证。
医脉通编译整理自:Maalej A,Khallouli A,Choura R,et al.The effects of hyperbaric oxygen therapy on diabetic retinopathy: A preliminary study[J].J Fr Ophtalmol2020 Feb;43(2):133-138.